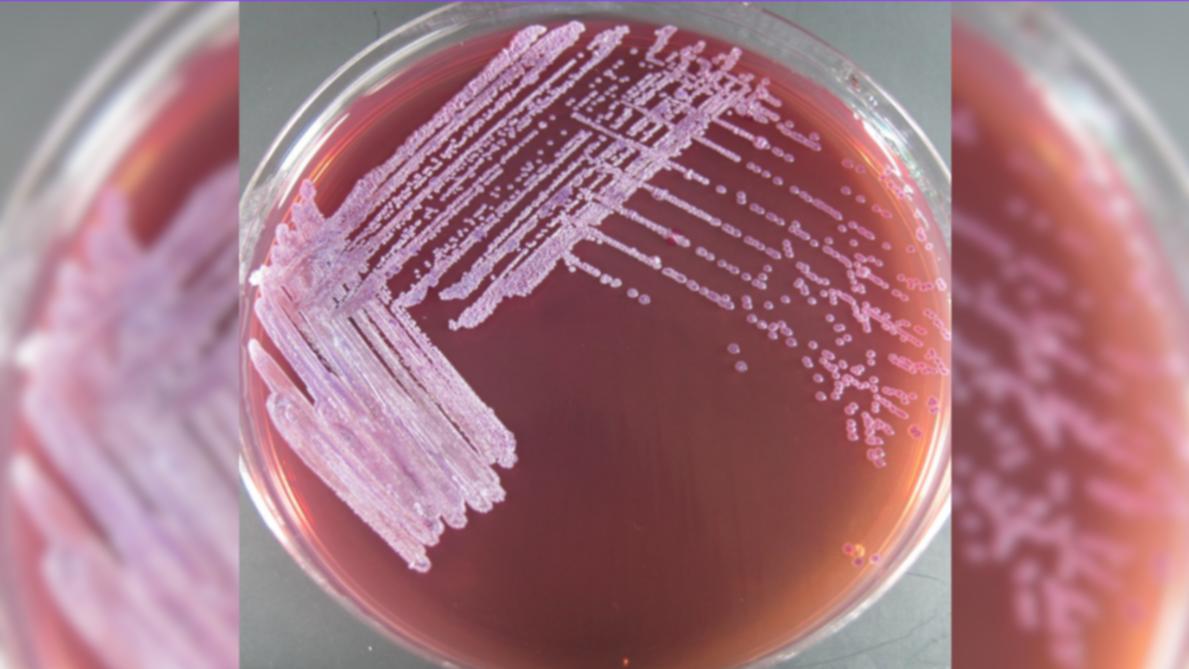
افزایش مرگ و میر ناشی از بیماری خطرناک ملیوئیدوز، در شمال ایالت کوئینزلند

شیوع یک بیماری باکتریایی خطرناک در شمال کوئینزلند، قربانی شدن چهار نفر دیگر را در پی داشته است.
به گزارش رادیونشاط، تاکنون 12 نفر بر اثر ابتلا به این بیماری جانشان را از دست دادهاند. جنوب کرنز به کانون اصلی این بیماری تبدیل شده و ۹ مورد از ۱۲ مرگ گزارششده در این منطقه رخ داده است. در تاونزویل نیز متاسفانه ۳ نفر بر اثر این بیماری جان باختهاند.
به گزارش وزارت بهداشت کوئینزلند از اول ژانویه تاکنون ابتلای 53 بیمار به ملیوئیدوز در شمال این ایالت به ثبت رسیده است. کارشناسان بهداشت در تلاشند تا علت افزایش ناگهانی موارد ابتلا به ملیوئیدوز را در شمال کوئینزلند شناسایی کنند.
مدیر خدمات بهداشت عمومی مناطق گرمسیری در وزارت بهداشت کوئینزلند گفت، افرادی که از بیماریهای زمینهای مانند دیابت، مشکلات کلیوی، مشکلات ریوی رنج میبرند و همچنین افرادی که داروهایی مصرف میکنند که سیستم ایمنی بدن آنها را تضعیف میکند،بیشتر در معرض خطر بوده و باید بهتر از خودشان مراقبت کنند.
باکتری عامل این بیماری، "بورخولدریا سودومالی"، معمولاً در خاک و آب مناطق گرمسیری یافت میشود. بارانهای شدید میتواند خاک و آبهای سطحی منتقرا به این باکتری آلوده کند.
انتقال ملیوئیدوز به انسان از طریق تماس مستقیم پوست آسیبدیده (بریدگی یا زخم) با خاک یا آب آلوده و یا استنشاق گرد و غبار یا قطرات آلوده صورت میگیرد.
اگرچه ملیوئیدوز در افراد بزرگسال سالم نادر است، اما افراد دارای بیماریهای زمینهای و کسانی که سیستم ایمنی ضعیفی دارند، بیشتر در معرض خطر ابتلا به این بیماری و عوارض جدی آن هستند.
علائم ملیوئیدوز حاد میتواند شامل تب، سرفه و تنگی نفس باشد. این بیماری همچنین میتواند به صورت عفونتهای پوستی و آبسههای مختلف در بدن ظاهر شود. درمان ملیوئیدوز معمولاً نیازمند بستری شدن در بیمارستان و دریافت آنتیبیوتیک است.